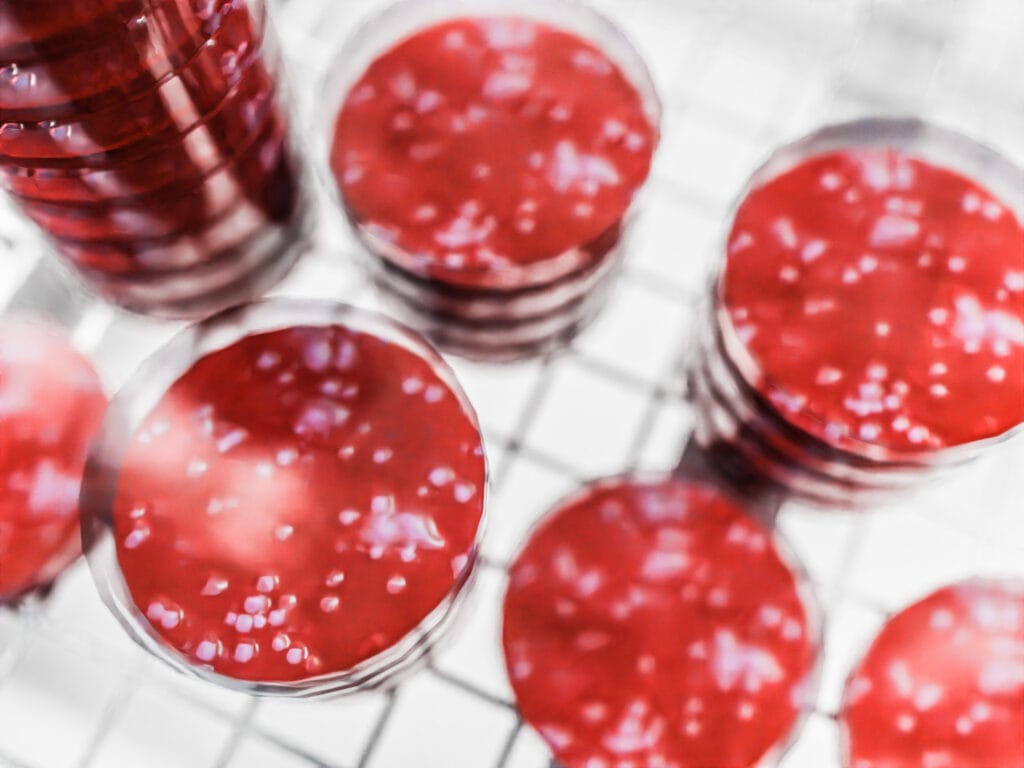

Incubation Reach-in Chambers
Incubation Reach-In Chambers by Biora are available in a range of sizes, from 240 – 1400L; providing complete control over environmental conditions.
Units are provided with shelves and lighting on request, allowing clients to customise their unit specifically for their sample testing requirements.
Designed to provide a contaminant-free environment, they can replicate any temperature, humidity, lighting, pressure, and gas concentration within the internal atmosphere.
Details
- Various sizes available, from 240-1400L
- Coated steel construction with insulated doors
- HMI control system with intuitive programming
- Adaptable, multi-tier tissue culture-spec shelving
- Large range of individually adjustable LED lighting
- Upward air flow to minimise condensation
- Temperature control
- Security upgrades (optional)
- CO2 monitoring and enrichment (optional)
- Remote web-based chamber monitoring and control (optional)
- Reverse Osmosis Water Recycling Kit (optional)
HMI Control System
- Web-based software with both local and remote access
- Real-time monitoring of all control processes
- Access to historical data
- Over 50 customisable programs
- Data export and import options
- Push notifications based on custom alert settings
- Data protection and security options
- Customised HMI options and local engineering support
240L RIC
- 2 tier, benchtop size
- Exterior: 800W x 930D x 1360H
- Growth area: 0.39m2 to 0.79m2
- Growth height: 290mm to 600mm
480L RIC
- 4 tier
- Exterior: 900W x 950D x 1950H
- Growth Area: 0.42m2 to 1.68m2
- Growth Height: 250 to 1000mm
600L RIC
- 4 tier
- Exterior:900W x 1040D x 1950H
- Growth Area: 0.46m2 to 1.80m2
- Growth Height: 290 to 1240mm
800L RIC
- 3 tier
- Exterior: 1070W x 990D x 1950H
- Growth area: 0.6m2 to 1.9m2
- Growth height: 380mm to 1200mm
1200L RIC
- 4 tier
- Exterior: 1700W x 910D x 2070H
- Growth Area: 1.0m2 to 4.1m2
- Growth Height: 270mm to 1200mm
1400L RIC
- 4 tier
- Exterior: 2050W x 925D x 2075H
- Growth Area: 0.9m2 to 3.8m2
- Growth Height: 340mm to 1400mm
Related Products
LED Glasses – Biora Method Seven Eyewear
LED Glasses – Biora Method Seven Eyewear LED Glasses for grow rooms, designed by Method Seven, deliver the world’s first glasses formulated to light balance and compensate for the unique spectrum of LED grow lights. Unique LED lens technology and highest quality materials provide exceptional colour and clarity, as well as 100% UV protection. This
HPS Glasses – Biora Method Seven Eyewear
HPS Glasses – Biora Method Seven Eyewear Biora’s HPS Glasses for grow rooms, designed by Method Seven, feature unique mineral glass lenses that deliver perfect colour balancing in the intense yellow spectrum and harsh visual conditions of HPS lighting environments. Tuned and tested for grow environments, Biora Method Seven HPS eyewear is available in a
Camera Lens Filters – Biora Method Seven
Camera Lens Filters – Biora Method Seven With Biora’s range of LED and HPS Camera Lens Filters, you can capture amazing, perfect colour photos and videos inside your grow room. Specially formulated photo filter lenses balance light output of popular LED and HPS lights. Biora camera filters are housed in anodized aluminium and compatible with






